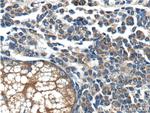
BRAF Antibody in Immunohistochemistry (Paraffin) (IHC (P))

Search
Proteintech
BRAF Polyclonal Antibody
{{$productOrderCtrl.translations['antibody.pdp.commerceCard.promotion.promotions']}}
{{$productOrderCtrl.translations['antibody.pdp.commerceCard.promotion.viewpromo']}}
{{$productOrderCtrl.translations['antibody.pdp.commerceCard.promotion.promocode']}}: {{promo.promoCode}} {{promo.promoTitle}} {{promo.promoDescription}}. {{$productOrderCtrl.translations['antibody.pdp.commerceCard.promotion.learnmore']}}
产品信息
20899-1-AP
种属反应
宿主/亚型
分类
类型
抗原
偶联物
形式
浓度
规格
纯化类型
保存液
内含物
保存条件
运输条件
产品详细信息
Immunogen sequence: NEVGVLRKT RHVNILLFMG YSTKPQLAIV TQWCEGSSLY HHLHIIETKF EMIKLIDIAR QTAQGMDYLH AKSIIHRDLK SNNIFLHEDL TVKIGDFGLA TVKSRWSGSH QFEQLSGSIL WMAPEVIRMQ DKNPYSFQSD VYAFGIVLYE LMTGQLPYSN INNRDQIIFM VGRGYLSPDL SKVRSNCPKA MKRLMAECLK KKRDERPLFP QILASIELLA RSLPKIHRSA SEPSLNRAGF QTEDFSLYAC ASPKTPIQAG GYGAFPVH (500-766 aa encoded by BC101757)
靶标信息
BRAF is involved in the transduction of mitogenic signals from the cell membrane to the nucleus. It is activated by somatic point mutation in human cancer, and is thought to play a role in the postsynaptic responses of hippocampal neuron. This protein plays a role in regulating the MAP kinase/ERKs signaling pathway, which affects cell division, differentiation, and secretion. Mutations in B-Raf have also been associated with various cancers, including non-Hodgkin lymphoma, colorectal cancer, malignant melanoma, thyroid carcinoma, non-small cell lung carcinoma, and adenocarcinoma of lung. A pseudogene, which is located on chromosome X, has been identified for B-Raf.
仅用于科研。不用于诊断过程。未经明确授权不得转售。
生物信息学
蛋白别名: 94 kDa B-raf protein; B-Raf proto-oncogene serine/threonine-protein kinase (p94); B-Raf serine/threonine-protein; FLJ95109; MGC126806; murine sarcoma viral (v-raf) oncogene homolog B1; p94; Proto-oncogene B-Raf; serine/threonine protein kinase; Serine/threonine-protein kinase B-raf; v-raf murine sarcoma viral oncogene homolog B; v-Raf murine sarcoma viral oncogene homolog B1
基因别名: 9930012E13Rik; AA120551; AA387315; AA473386; B-raf; B-RAF1; BRAF; BRAF-1; Braf-2; BRAF1; Braf2; C230098H17; C87398; D6Ertd631e; NS7; RAFB1
UniProt ID: (Human) P15056, (Mouse) P28028
Entrez Gene ID: (Human) 673, (Mouse) 109880